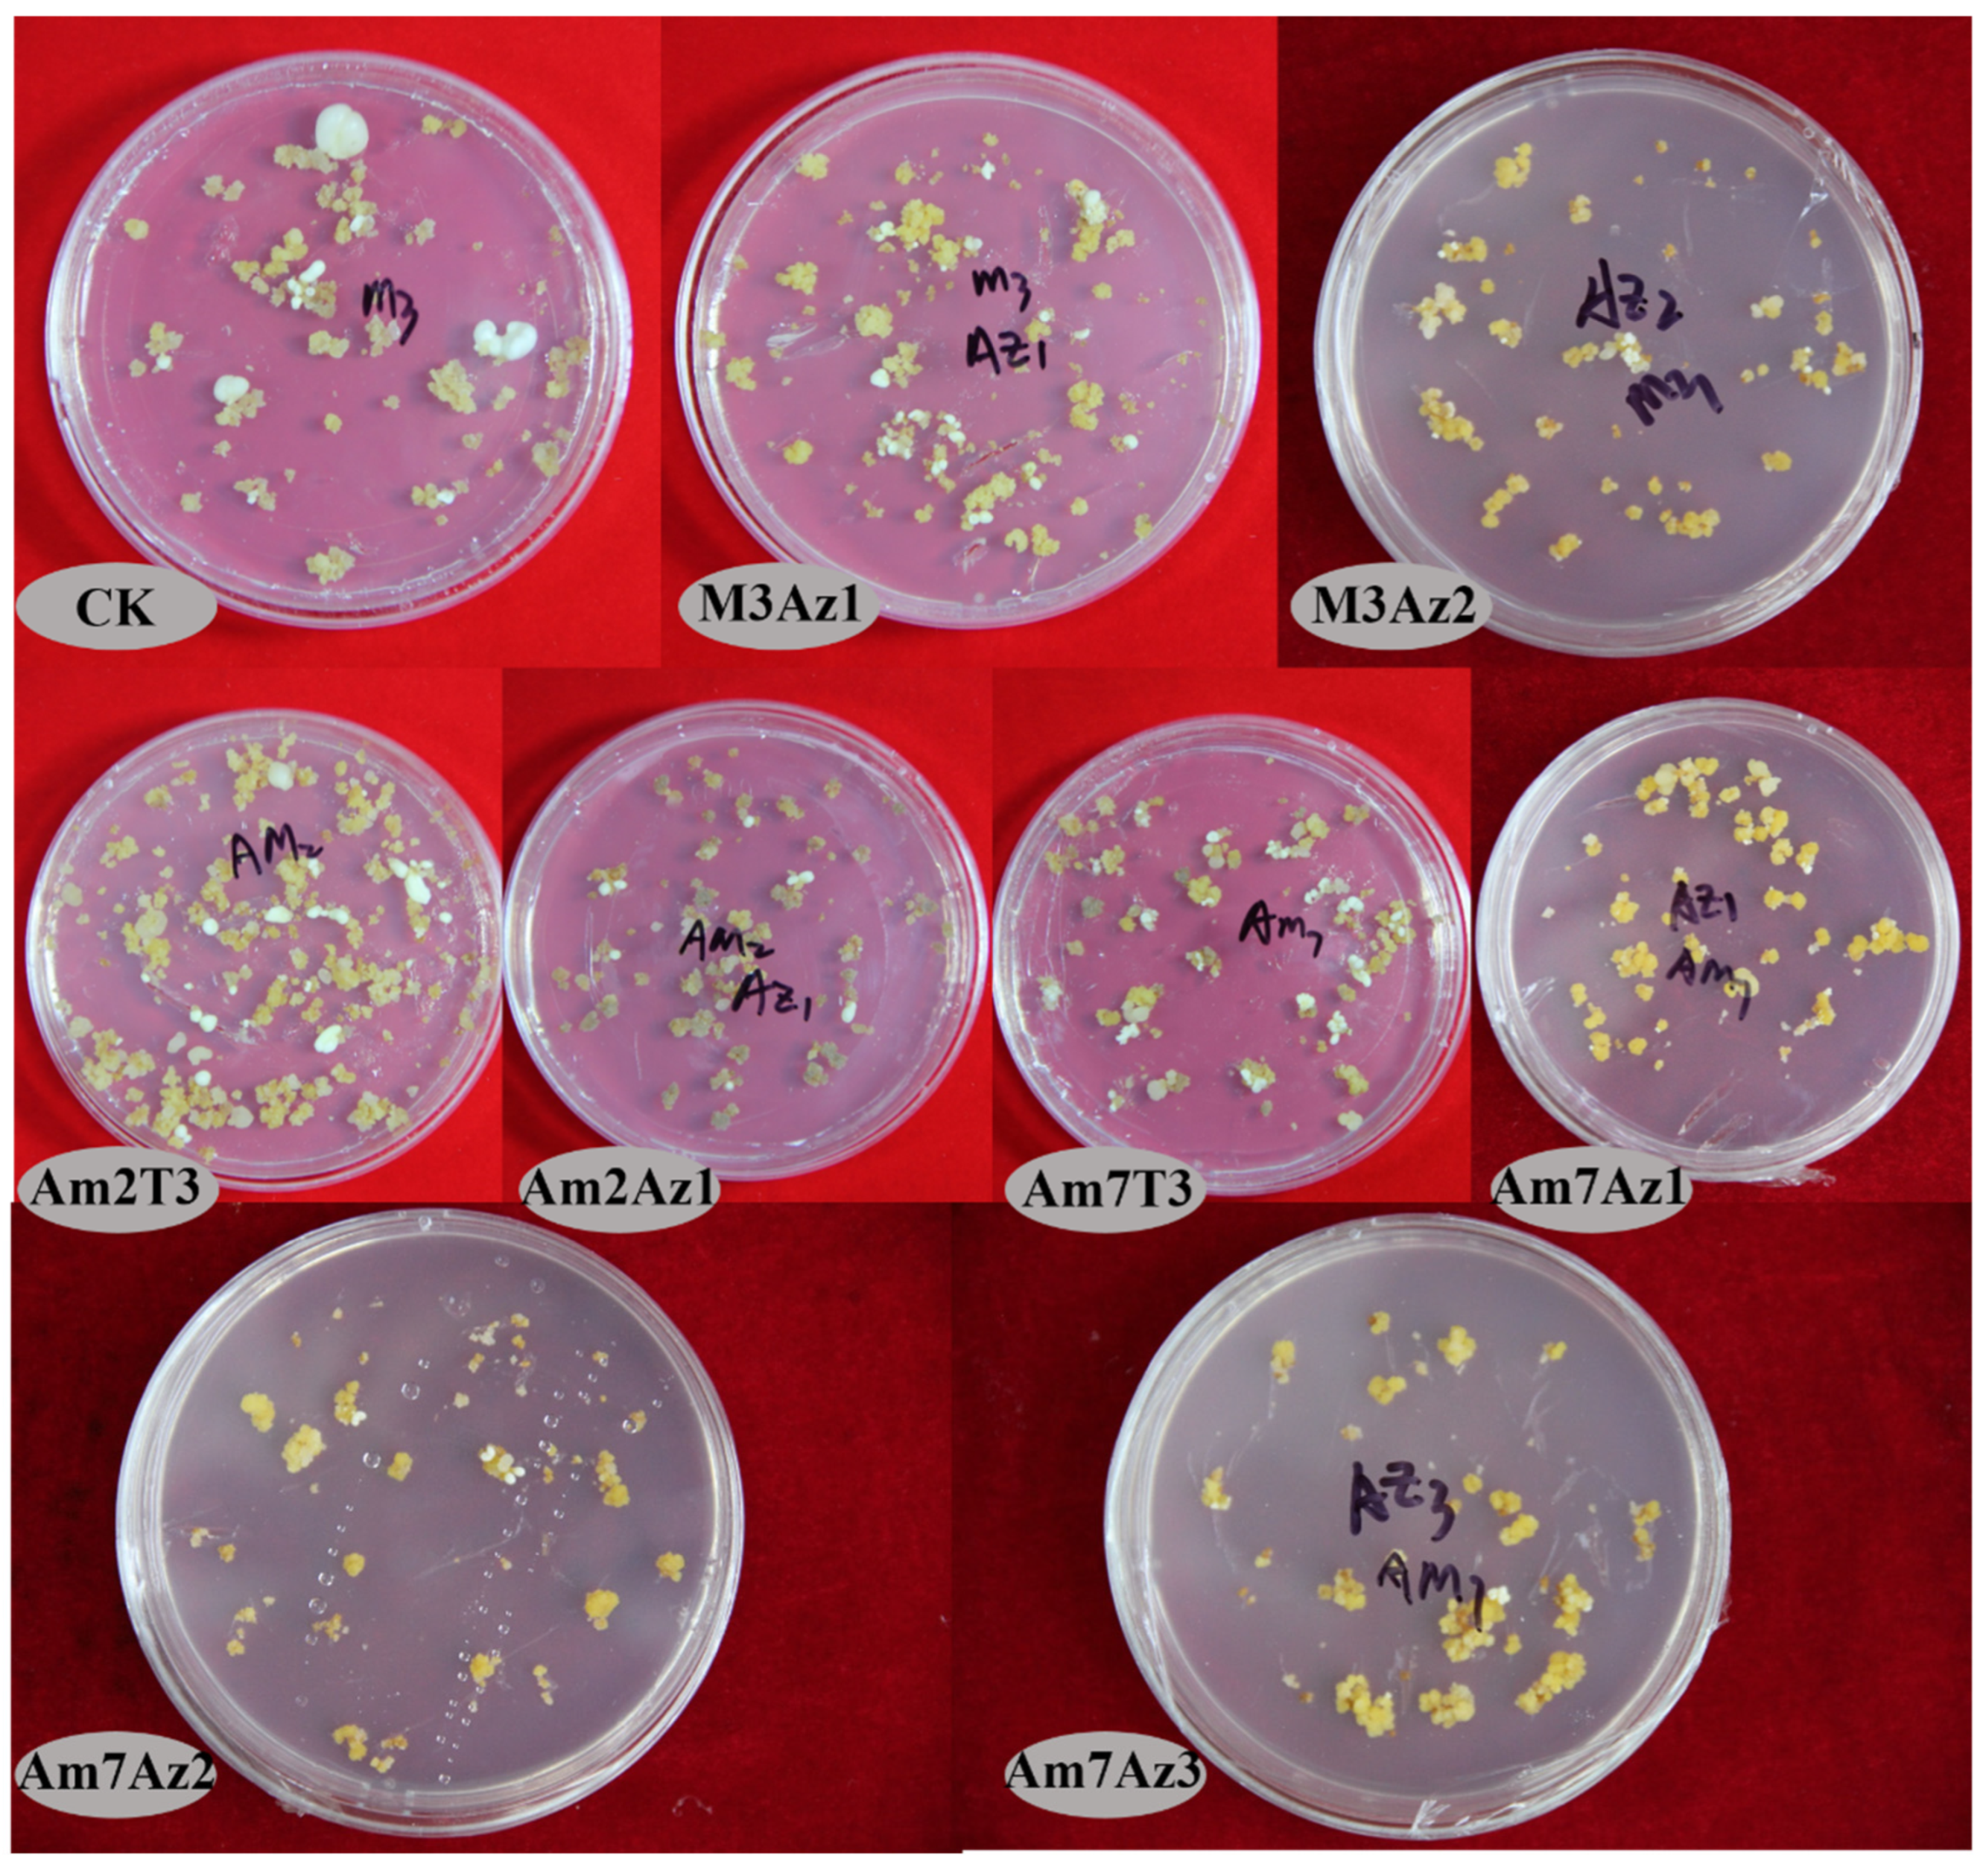

Effects of Amino Acids on Callus Proliferation and Somatic Embryogenesis in Litchi chinensis cv. ‘Feizixiao’
Abstract
1. Introduction
2. Materials and Methods
2.1. Callus Induction and Culture
- Experiment 1
2.2. AA Quantification Using High-Performance Liquid Chromatography (HPLC)
- Experiment 2
2.3. The Addition of AAs to the Proliferation Medium
2.4. Histology of AMO1-Proliferated Callus
- Experiment 3
2.5. The Addition of AA to the Somatic Embryo Induction Medium
2.6. Data Analysis
3. Results
3.1. AA Contents during Callus Proliferation
3.2. AA Contents during Somatic Embryo Induction
3.3. Effects of AMO1 on the Callus Proliferation Index and Somatic Embryo Induction and Regeneration
3.4. Histological and Morphological Changes
3.5. Effects of the Combination of AMO1 and AMO2 on Somatic Embryogenesis and Regeneration
4. Discussion
5. Conclusions
Author Contributions
Funding
Institutional Review Board Statement
Data Availability Statement
Acknowledgments
Conflicts of Interest
References
- Hu, G.B.; Feng, J.T.; Xiang, X.; Wang, J.B.; Jarkko, S.; Liu, C.M.; Wu, Z.X.; Zhang, J.S.; Liang, X.M.; Jiang, Z.D.; et al. Two divergent haplotypes from a highly heterozygous lychee genome suggest independent domestication events for early and late-maturing cultivars. Nat. Genet. 2022, 54, 73–83. [Google Scholar] [CrossRef] [PubMed]
- Das, D.K.; Rahman, A. Expression of a bacterial chitinase (ChinB) gene enhances antifungal potential in transgenic Litchi Chinensis Sonn. (Bedana). Curr. Trends Biotechnol. Pharm. 2010, 4, 820–833. [Google Scholar]
- Wang, G.; Li, H.L.; Wang, S.J.; Sun, J.H.; Zhang, X.C.; Wang, J.B. In vitro regeneration of litchi (Litchi chinensis Sonn.). Afr. J. Biotechnol. 2016, 15, 1026–1034. [Google Scholar] [CrossRef]
- Das, D.K.; Rahman, A.; Kumari, D.; Kumari, N. Synthetic seed preparation, germination and plantlet regeneration of Litchi (Litchi chinensis Sonn.). Am. J. Plant Sci. 2016, 7, 1395–1406. [Google Scholar] [CrossRef]
- Anjani, K.; Kumar, H. In vitro studies in Litchi chinensis–effect of explant and medium. Int. J. Curr. Microbiol. Appl. Sci. 2018, 7, 2413–2422. [Google Scholar] [CrossRef]
- Yu, C.; Chen, Z.; Lu, L.; Lin, J.W. Somatic embryogenesis and plant regeneration from litchi protoplasts isolated from embryogenic suspensions. Plant Cell Tissue Organ Cult. 2000, 61, 51–58. [Google Scholar] [CrossRef]
- Puchooa, D. In vitro regeneration of lychee (Litchi chinensis Sonn.). Afr. J. Biotechnol. 2004, 3, 576–584. [Google Scholar]
- He, Y.Q.; Cheng, J.P.; He, Y.; Yang, B.; Cheng, Y.H.; Yang, C.; Zhang, H.S.; Wang, Z.F. Influence of isopropyl malate synthase OsIPMS1 on seed vigor associated with amino acid and energy metabolism in rice. Plant Biotechnol. J. 2019, 17, 322–337. [Google Scholar] [CrossRef]
- Rahmouni, S.; Ansari, Z.N.E.; Badoc, A.; Martin, P.; Kbiach, M.L.E.; Lamarti, A. Effect of amino acids on secondary somatic embryogenesis of Moroccan Cork Oak (Quercus suber L.). Tree. Am. J. Plant Sci. 2020, 11, 626–641. [Google Scholar] [CrossRef]
- Bai, M.Y.; Lv, S.S.; Xia, X.Y. Effects of γ-aminobutyric acid on the growth and related physiological characteristics of Vaccinium plantlets in vitro. Plant Physiol. J. 2022, 58, 577–586. [Google Scholar] [CrossRef]
- Satish, L.; Rathinapriya, P.; Ceasar, S.A.; Rency, A.S.; Pandian, S.; Rameshkumar, R.; Subramanian, A.; Ramesh, M. Effects of cefotaxime, amino acids and carbon source on somatic embryogenesis and plant regeneration in four Indian genotypes of foxtail millet (Setaria italica L.). Vitr. Cell. Dev. Biol. Plant 2015, 52, 140–153. [Google Scholar] [CrossRef]
- Chen, T.T.; Yang, D.J.; Fan, R.F.; Zeng, R.H.; Lu, Y.; Chen, T.L.; Shi, J.S.; Chen, J.H. γ–Aminobutyric acid a novel candidate for rapid induction in somatic embryogenesis of Liriodendron hybrid. Plant Growth Regul. 2022, 96, 293–302. [Google Scholar] [CrossRef]
- Garin, E.; Bernier–Cardou, M.; Isabel, N.; Klimaszewska, K.; Plourde, A. Effect of sugars, amino acids, and culture technique on maturation of somatic embryos of Pinus strobus on medium with two gellan gum concentrations. Plant Cell Tissue Organ Cult. 2000, 62, 27–37. [Google Scholar] [CrossRef]
- Robichaud, R.L.; Lessard, V.C.; Merkle, S.A. Treatments affecting maturation and germination of American chestnut somatic embryos. J. Plant Physiol. 2004, 161, 957–969. [Google Scholar] [CrossRef] [PubMed]
- Ramakrishnan, M.; Ceasar, S.A.; Duraipandiyan, V.; Daniel, M.A.; Ignacimuthu, S. Efficacious somatic embryogenesis and fertile plant recovery from shoot apex explants of onion (Allium cepa. L.). Vitr. Cell. Dev. Biol. Plant 2013, 49, 285–293. [Google Scholar] [CrossRef]
- Asthana, P.; Rai, M.K.; Jaiswal, U. Somatic embryogenesis from sepal explants in Sapindus trifoliatus, a Plant Valuable in Herbal Soap Industry. Ind. Crops Prod. 2017, 100, 228–235. [Google Scholar] [CrossRef]
- Fu, L.F.; Tang, D.Y. Induction pollen plants of litchi tree (Litchi chinensis Sonn.). Acta Genet. Sin. 1983, 10, 369–374. [Google Scholar] [CrossRef]
- Fan, C.N.; Liu, G.J. Study on callus induction of litchi young leaves. China Fruits 2006, 03, 25–27. [Google Scholar] [CrossRef]
- Raharjo, S.H.T.; Litz, R.E. Somatic embryogenesis and plant regeneration of litchi (Litchi Chinensis Sonn.) from leaves of mature phase trees. Plant Cell Tissue Organ Cult. 2007, 89, 113–119. [Google Scholar] [CrossRef]
- Dhillon, M.K.; Kumar, S. Amino acid profiling of Sorghum bicolor vis-à-vis Chilo partellus (Swinhoe) for biochemical interactions and plant resistance. Arthropod-Plant Interact. 2017, 11, 537–550. [Google Scholar] [CrossRef]
- Bach-Pages, M.; Preston, G.M. Methods to quantify biotic-induced stress in plants. Methods Mol. Biol. 2017, 19, 241–255. [Google Scholar] [CrossRef]
- Walther, M.; Wagner, I.; Raschke1, J.; Zoglauer, K.; Rupps, A. Abscisic acid induces somatic embryogenesis and enables the capture of high-value genotypes in Douglas fir (Pseudotsuga menziesii [MIRB.] Franco). Plant Cell Tissue Organ Cult. 2022, 148, 45–59. [Google Scholar] [CrossRef]
- Tang, Q.Y. Data Processing System-Experimental Design, Statistical Analysis and Data Mining (Second Edition). 2010. Available online: www.sciencep.com (accessed on 7 October 2023).
- Wang, G.; Liu, Y.T.; Wang, J.B.; Li, H.L. Study on the optimization of amino acids on proliferation of calli and somatic embryogenesis in Litchi chinensis Sonn. cv. Feizixiao. J. Fruit Sci. 2023, 40, 2466–2476. [Google Scholar] [CrossRef]
- Malabadi, R.B.; Van Staden, J. Somatic embryogenesis from vegetative shoot apices of mature trees of Pinus patula. Tree Physiol. 2005, 25, 11–16. [Google Scholar] [CrossRef] [PubMed]
- Niemenak, N.; Saare-Surminski, K.; Rohsius, C.; Ndoumou, D.O.; Lieberei, R. Regeneration of somatic embryos in Theobroma cacao L. in temporary immersion bioreactor and analyses of free amino acids in different tissues. Plant Cell Rep. 2008, 27, 667–676. [Google Scholar] [CrossRef]
- Murch, S.J.; Victor, J.M.R.; Krishnaraj, S.; Saxena, P.K. The role of proline in thidiazuron-induced somatic embryogenesis of peanut. Vitr. Cell. Dev. Biol. Plant. 1999, 35, 102–105. [Google Scholar] [CrossRef]
- Martínez, M.T.; San José, M.C.; Vieitez, A.M.; Cernadas, M.J.; Ballester, A.; Corredoira, E. Propagation of mature Quercus ilex L. (Holm Oak) trees by somatic embryogenesis. Plant Cell Tissue Organ Cult. 2017, 131, 321–333. [Google Scholar] [CrossRef]
- Von Arnold, S. Improved efficiency of somatic embryogenesis in mature embryos of Picea abies (L.) Karst. J. Plant Physiol. 1987, 128, 233–244. [Google Scholar] [CrossRef]
- Zavattieri, M.A.; Frederico, A.M.; Lima, M. Induction of somatic embryogenesis as an example of stress-related plant reactions. Electron. J. Biotechnol. 2010, 13, 12–13. [Google Scholar] [CrossRef]
- Pinto, G.; Valentim, H.; Costa, A.; Castro, S.; Santos, C. Somatic embryogenesis in leaf callus from a mature Quercus suber L. Tree. Vitr. Cell. Dev. Biol.-Plant 2002, 38, 569–572. [Google Scholar] [CrossRef]
- Barrett, J.D.; Park, Y.S.; Bonga, J.M. The effectiveness of various nitrogen sources in White Spruce [Picea glauca (Moench) Voss] Somatic Embryogenesis. Plant Cell Rep. 1997, 16, 411–415. [Google Scholar] [CrossRef] [PubMed]
- Daniel, M.A.; Host, A.D.R.; Antony, C.S.; Ramakrishnan, M.; Duraipandiyan, V.; Ignacimuthu, S.; Al-Dhabi, N.A. Effect of L-glutamine and casein hydrolysate in the development of somatic embryos from cotyledonary leaf explants in Okra (Abelmoschus esculentus L. Monech). South Afr. J. Bot. 2018, 114, 223–231. [Google Scholar] [CrossRef]
- Ashok, K.H.G.; Murthy, H.N. Effects of sugars and amino acids on androgenesis of Cucumis sativus. Plant Cell Tissue Organ Cult. 2004, 78, 201–208. [Google Scholar] [CrossRef]
- Pintos, B.; Manzaneraj, A.; Bueno, M.A. Oak somatic and gametic embryos maturation is affected by charcoal and specific amino acids mixture. Ann. For. Sci. 2010, 67, 205. [Google Scholar] [CrossRef][Green Version]
- Kong, Y.Y.; Biddle, J.; Kalaipandian, S.; Adkins, S.W. Coconut callus initiation for cell suspension culture. Plants 2023, 12, 968. [Google Scholar] [CrossRef] [PubMed]
- Maruyama, T.E.; Ueno, S.; Mori, H.; Kaneeda, T.; Moriguchi, Y. Factors influencing somatic embryo maturation in Sugi (Japanese Cedar, Cryptomeria japonica (Thunb. ex L.f.) D. Don). Plants 2021, 10, 874. [Google Scholar] [CrossRef] [PubMed]

| Media | Composition | Functions |
|---|---|---|
| MS | Contains the macro- and micronutrients and vitamins as described by Murashige and Skoog (1962) | Basal medium |
| M1 | MS, 2 mg·L−1 2,4-dichlorophenoxyacetic acid, 30 g·L−1 sucrose, 7 g·L−1 agar, pH 5.8 | Induction of callus |
| M3 | MS, 1 mg·L−1 2,4-dichlorophenoxyacetic acid, 30 g·L−1 sucrose, 7 g·L−1 agar, pH 5.8 | Initiation and maintenance of EC |
| M4 | MS, 1 mg·L−1 2,4-dichlorophenoxyacetic acid, 0.5 mg·L−1 kinetin, 5 mg·L−1 silver nitrate, 30 g·L−1 sucrose, 7 g·L−1 agar, pH 5.8 | Initiation and maintenance of EC |
| T3 | MS, 0.1 mg·L−1 1-naphthaleneacetic acid, 5 mg·L−1 kinetin, 0.1 g·L−1 myo-inositol, 0.4 g·L−1 lactoalbumin hydrolysate, 100 mL·L−1 coconut water, 60 g·L−1 sucrose, 10 g·L−1 agar, pH 5.8 | Induction of somatic embryos from EC |
| C19 | MS, 0.5 mg·L−1 indole-3-acetic acid, 1 mg·L−1 abscisic acid, 100 mL·L−1 coconut milk, 60 g·L−1 sucrose, 10 g·L−1 agar, pH 5.8 | Maturation of somatic embryos |
| 1/2 MS | Contains 1/2 the macro- and micronutrients as described by Murashige and Skoog (1962) | Basal medium |
| R7 | 1/2 MS, 30 g·L−1 sucrose, 0.5 mg·L−1 gibberellic acid, 7 g·L−1 agar, pH 5.8 | Germination of somatic embryos |
| No. | AA | Amino Acid (AA) Contents (μg·gFW−1) during Callus Proliferation | LSD | Average | Percentage | ||||||||
|---|---|---|---|---|---|---|---|---|---|---|---|---|---|
| 0 d | 3 d | 6 d | 9 d | 12 d | 15 d | 18 d | 21 d | 24 d | |||||
| 1 | GABA | 1101.7 | 855.3 | 922.7 | 1004.6 | 2165.2 | 1242.3 | 1029.1 | 2133.6 | 1286.3 | 591.7 | 1304.6 | 21.8% |
| 2 | Ala | 687.3 | 694.1 | 711.4 | 755.4 | 1118.1 | 722.2 | 669.3 | 1207.5 | 641.9 | 339.7 | 800.8 | 13.4% |
| 3 | Arg | 1142.2 | 416.5 | 541.4 | 538.7 | 598.1 | 570.5 | 1348.5 | 688.1 | 997.6 | 738.8 | 760.2 | 12.7% |
| 4 | Gln | 698.4 | 639.5 | 403.7 | 553.3 | 612 | 822.1 | 764.8 | 722.9 | 656.2 | 177.9 | 652.5 | 10.9% |
| 5 | Pro | 407.3 | 383 | 433.4 | 491.9 | 463 | 354.7 | 498.5 | 626.5 | 334.4 | 82.9 | 443.6 | 7.4% |
| 6 | Leu | 385 | 139.6 | 357.3 | 390 | 368.4 | 368.3 | 326.8 | 368.3 | 279.5 | 158.3 | 331.5 | 5.5% |
| 7 | Glu | 260.4 | 91.1 | 169.5 | 285.2 | 415.2 | 309.3 | 341.3 | 433.6 | 351.7 | 136.3 | 295.3 | 4.9% |
| 8 | Phe | 143.2 | 176.1 | 173.5 | 206.7 | 253.8 | 228.2 | 227.7 | 201 | 173.9 | 58.7 | 198.2 | 3.3% |
| 9 | Ile | 185.5 | 262.7 | 164.5 | 185.5 | 186.9 | 175.6 | 160.9 | 145.2 | 129.4 | 105.1 | 177.4 | 3.0% |
| 10 | Val | 162.3 | 175.8 | 153.9 | 167.1 | 181.6 | 146.9 | 150.5 | 188.1 | 116.5 | 25.1 | 160.3 | 2.7% |
| 11 | Ser | 125.5 | 119.2 | 130.4 | 134.6 | 172.3 | 125.1 | 154.6 | 203.8 | 123.4 | 35.4 | 143.2 | 2.4% |
| 12 | Asp | 135.1 | 94 | 113.8 | 102 | 176.7 | 100.9 | 138.3 | 171.6 | 98.8 | 31 | 125.7 | 2.1% |
| 13 | Thr | 89.4 | 72.7 | 81 | 86.2 | 107.1 | 75.9 | 223.2 | 126.7 | 97.3 | 124 | 106.6 | 1.8% |
| 14 | Lys | 104.4 | 93.4 | 93.7 | 106.1 | 125.6 | 108.6 | 109.9 | 112 | 98.8 | 20.6 | 105.8 | 1.8% |
| 15 | Asn | 72.6 | 61.1 | 67 | 77.4 | 89.7 | 77.4 | 98.8 | 125.2 | 77.3 | 22 | 82.9 | 1.4% |
| 16 | His | 73.1 | 69.4 | 57.9 | 61.2 | 89.4 | 91.3 | 86.9 | 115.3 | 80.9 | 26.8 | 80.6 | 1.3% |
| 17 | Tyr | 65.3 | 62.7 | 61.3 | 63.9 | 76.7 | 65.4 | 63.5 | 79.9 | 62.3 | 11.9 | 66.8 | 1.1% |
| 18 | Cys | 18.1 | 120.3 | 17.9 | 17.9 | 58.4 | 53.5 | 58.7 | 56.9 | 52.8 | 11.9 | 50.5 | 0.8% |
| 19 | Gly | 36.3 | 31.9 | 34 | 39.1 | 53.3 | 40.2 | 46 | 51.9 | 44.5 | 12.8 | 41.9 | 0.7% |
| 20 | Trp | 17.6 | 46.5 | 49.4 | 52.2 | 51.3 | 47.6 | 18.4 | 46.1 | 45.2 | 8.7 | 41.6 | 0.7% |
| 21 | Met | 23.3 | 23.1 | 23.4 | 25.6 | 25.4 | 26.2 | 23.8 | 23.6 | 22 | 6.6 | 24 | 0.4% |
| Total | 5933.9 | 4627.9 | 4761.1 | 5344.6 | 7388.2 | 5752.1 | 6539.6 | 7827.8 | 5770.7 | 828.2 | 5994.0 | 100.0% | |
| No. | Amino Acid (AA) Contents (μg·gFW−1) during Somatic Embryogenesis | LSD | Average | Percentage | |||||
|---|---|---|---|---|---|---|---|---|---|
| AA | 0 d | 5 d | 10 d | 15 d | 20 d | ||||
| 1 | GABA | 1538.8 | 902.4 | 857.8 | 1181.8 | 896.8 | 338.4 | 1075.5 | 22.2% |
| 2 | Arg | 1340.8 | 586.3 | 452.8 | 618.5 | 636.3 | 182.3 | 727.0 | 15.0% |
| 3 | Gln | 772.9 | 753.2 | 284.3 | 640 | 454.1 | 172.3 | 580.9 | 12.0% |
| 4 | Ala | 778.2 | 508.6 | 355.5 | 467.3 | 635.1 | 319.5 | 548.9 | 11.3% |
| 5 | Leu | 418.2 | 326.7 | 216.3 | 400.5 | 364.3 | 82.5 | 345.2 | 7.1% |
| 6 | Pro | 378.7 | 228.8 | 270.1 | 297.7 | 297.9 | 69.1 | 294.7 | 6.1% |
| 7 | Val | 202.3 | 194.7 | 150.9 | 283.8 | 239.4 | 50.4 | 214.2 | 4.4% |
| 8 | Glu | 127.3 | 173.5 | 118.9 | 211.4 | 191.9 | 54.6 | 164.6 | 3.4% |
| 9 | Phe | 169.5 | 152.3 | 124.8 | 101.4 | 138.2 | 58.9 | 137.2 | 2.8% |
| 10 | Lys | 145.1 | 84.9 | 105.6 | 128.7 | 134.1 | 44.3 | 119.7 | 2.5% |
| 11 | Ile | 97 | 95.8 | 64.9 | 129.1 | 122.7 | 33.2 | 101.9 | 2.1% |
| 12 | His | 96.8 | 92.6 | 60 | 114.7 | 98 | 24.9 | 92.4 | 1.9% |
| 13 | Ser | 144.5 | 77.8 | 57 | 88.9 | 85.4 | 17.7 | 90.7 | 1.9% |
| 14 | Asp | 142.8 | 67.5 | 47.7 | 61 | 58.5 | 21.9 | 75.5 | 1.6% |
| 15 | Thr | 99.3 | 57.9 | 49.8 | 85.5 | 78.5 | 34.9 | 74.2 | 1.5% |
| 16 | Asn | 73.4 | 51 | 39 | 52.7 | 43.2 | 13.8 | 51.9 | 1.1% |
| 17 | Tyr | 57.1 | 29.1 | 36.1 | 42.2 | 41.6 | 12.6 | 41.2 | 0.8% |
| 18 | Trp | 57.5 | 38.6 | 35.4 | 25.5 | 31.6 | 11.2 | 37.7 | 0.8% |
| 19 | Cys | 31.7 | 30.6 | 32.8 | 36.3 | 34.6 | 6.5 | 33.2 | 0.7% |
| 20 | Gly | 37 | 23.4 | 22.7 | 30.6 | 30.9 | 0.1 | 28.9 | 0.6% |
| 21 | Met | 23.5 | 16.8 | 7.7 | 11.2 | 11.7 | 3.2 | 14.2 | 0.3% |
| Total | 6732.4 | 4492.5 | 3390.1 | 5008.8 | 4624.8 | 868.9 | 4849.7 | 100.0% | |
| No. | AA | Added to the Callus Proliferation Medium | Added to the Somatic Embryo Induction Medium | ||||||||
|---|---|---|---|---|---|---|---|---|---|---|---|
| Stock Concentration (g·L−1) | Final Concentration (mg·L−1) | Stock Concentration (g·L−1) | Final Concentration (mg·L−1) | ||||||||
| AMO1 | 1× | 5× | 10× | 15× | AMO2 | 1× | 5× | 10× | 15× | ||
| 1 | GABA | 43.5 | 43.5 | 217.7 | 435.3 | 653.0 | 44.4 | 44.4 | 221.8 | 443.5 | 665.3 |
| 2 | Ala | 26.7 | 26.7 | 133.6 | 267.2 | 400.8 | 30.0 | 30.0 | 149.9 | 299.8 | 449.7 |
| 3 | Arg | 25.4 | 25.4 | 126.8 | 253.7 | 380.5 | 24.0 | 24.0 | 119.8 | 239.6 | 359.3 |
| 4 | Gln | 21.8 | 21.8 | 108.9 | 217.8 | 326.6 | 22.6 | 22.6 | 113.2 | 226.4 | 339.6 |
| 5 | Pro | 14.8 | 14.8 | 74.0 | 148.0 | 222.1 | 14.2 | 14.2 | 71.2 | 142.4 | 213.5 |
| 6 | Leu | 11.1 | 11.1 | 55.3 | 110.6 | 165.9 | 12.2 | 12.2 | 60.8 | 121.5 | 182.3 |
| 7 | Glu | 9.9 | 9.9 | 49.3 | 98.5 | 147.8 | 8.8 | 8.8 | 44.2 | 88.3 | 132.5 |
| 8 | Phe | 6.6 | 6.6 | 33.1 | 66.2 | 99.2 | 6.8 | 6.8 | 33.9 | 67.9 | 101.8 |
| 9 | Ile | 5.9 | 5.9 | 29.5 | 59.1 | 88.6 | 5.7 | 5.7 | 28.3 | 56.6 | 84.9 |
| 10 | Val | 5.4 | 5.4 | 26.7 | 53.5 | 80.2 | 4.9 | 4.9 | 24.7 | 49.4 | 74.0 |
| 11 | Ser | 4.8 | 4.8 | 23.9 | 47.8 | 71.7 | 4.2 | 4.2 | 21.0 | 42.0 | 63.0 |
| 12 | Asp | 4.2 | 4.2 | 21.0 | 42.0 | 62.9 | 3.8 | 3.8 | 19.1 | 38.1 | 57.2 |
| 13 | Thr | 3.6 | 3.6 | 17.8 | 35.6 | 53.4 | 3.7 | 3.7 | 18.7 | 37.4 | 56.1 |
| 14 | Lys | 3.5 | 3.5 | 17.7 | 35.3 | 53.0 | 3.1 | 3.1 | 15.6 | 31.1 | 46.7 |
| 15 | Asn | 2.8 | 2.8 | 13.8 | 27.7 | 41.5 | 3.1 | 3.1 | 15.3 | 30.6 | 45.9 |
| 16 | His | 2.7 | 2.7 | 13.5 | 26.9 | 40.3 | 2.1 | 2.1 | 10.7 | 21.4 | 32.1 |
| 17 | Tyr | 2.2 | 2.2 | 11.1 | 22.3 | 33.4 | 1.7 | 1.7 | 8.5 | 17.0 | 25.5 |
| 18 | Cys | 1.7 | 1.7 | 8.4 | 16.9 | 25.3 | 1.6 | 1.6 | 7.8 | 15.6 | 23.3 |
| 19 | Gly | 1.4 | 1.4 | 7.0 | 14.0 | 21.0 | 1.4 | 1.4 | 6.9 | 13.7 | 20.5 |
| 20 | Trp | 1.4 | 1.4 | 6.9 | 13.9 | 20.8 | 1.2 | 1.2 | 6.0 | 11.9 | 17.9 |
| 21 | Met | 0.8 | 0.8 | 4.0 | 8.0 | 12.0 | 0.6 | 0.6 | 2.9 | 5.9 | 8.8 |
| Total | 200.0 | 200.0 | 1000.0 | 2000.0 | 3000.0 | 200.0 | 200.0 | 1000.0 | 2000.0 | 3000.0 | |
| Treatment | Calli and Somatic Embryo Morphology |
|---|---|
| CK | Yellow and hyperhydricity calluses, medium particles, a small number of white non-embryogenic calli (NECs), and transparent embryos. Elliptical cell. EC cells were lysed into flakes; EC cells began to lyse; the embryonic cells were small and deeply stained. Some opalescent embryos. The size of opalescent embryos varied greatly (0.1–1 cm); 0.5–1 cm opalescent embryos were globular, while 0.2–0.4 cm opalescent embryos were cotyledonous. Some calli grew and gradually became brown. |
| Am1 | Medium size and slight water stains; no proembryo; NEC initiated from the surface of an embryogenic callus (EC); yellow arrows indicate the NEC; blue arrows indicate the EC. Oblong cells, round and full (red arrow), contain more starch grains (red border). There were more embryonic cells, and the difference was obvious between the embryonic and the non-embryonic cells. The embryonic cells were small and heavily stained. The non-embryonic cells were large, the cell contents were thin, and the staining was shallow (yellow border). Some opalescent dicotyledonous embryos aggregated (0.3–0.5 cm), some globular embryos aggregated (0.7–0.9 cm), and some calli grew and gradually browned. |
| Am2 | Yellow callus, medium particles, more white NECs, no proembryo differentiation; proembryos initiated from the surface of the callus; a red rectangle indicates the proembryos. Many single cells or small cell masses, round cells, and abundant plastids. NEC cells were lightly stained and cleaved into flakes; EC cells and embryonic cells began to lyse. Dicotyledonous embryos (0.2 cm; black border) and transparent embryos. |
| Am3 | Brown and more transparent embryos. Most cells are undergoing lysis and apoptosis: triangular cells, shriveled cells, and deformed cells. A large number of proembryos (red border) and embryogenic and non-embryogenic structures are clearly demarcated. All the transparent embryos were brown and dead. |
| Am4 | Brown, grainy embryos with no growth. Cell lysis and apoptosis. A large number of cells gradually lysed (green border). All the calli were brown and dead. |
| Treatments | Calli and Somatic Embryo Morphology |
|---|---|
| CK | Yellow callus, medium particles, slight water, a small number of white non-embryogenic calli (NECs), and transparent embryos. Round cells and more proembryos. EC cells were lysed into flakes; embryogenic callus (EC) cells began to lyse; the embryonic cells were small and deeply stained. Some opalescent somatic embryos. The opalescent somatic embryos varied greatly in size (0.1–1 cm); 0.5–1 cm opalescent somatic embryos were globular, while 0.2–0.4 cm opalescent somatic embryos were cotyledon. Some callus grew and gradually browned. |
| Am1 | Medium size and slight water stains, mixed with NECs, no proembryo. Oblong cells, round and full, have more starch grains. There were more embryonic cells, and the difference was obvious between the embryonic and the non-embryonic cells. The embryonic cells were small and stained heavily. The non-embryonic cells were large, the cell contents were thin, and the staining was shallow. Some opalescent dicotyledonous embryos aggregated (0.3–0.5 cm), some globular embryos aggregated (0.7–0.9 cm), and some calli grew and gradually browned. |
| Am5 | Yellow and coarse callus, white transparent embryos, and opalescent globular embryos. Large callus and isolated round cells. Large EC cells, thick cell walls, and more proembryos. Dicotyledon embryo (0.2 cm), yellow callus. |
| Am6 | Dark yellow callus, a small number of NECs, and transparent and opalescent globular embryos. Mostly multicellular proembryos, and more starch grains in the cell mass. Vigorous EC cell division leads to more proembryos. Dicotyledon embryo (0.4 cm) and opalescent globular embryo (0.1 cm). |
| Am7 | Tiny callus, more white NECs, no proembryo differentiation. Small round cells, many dividing and proliferating cells. A small number of multicellular problasts; uniform and vigorous division of EC cells; no NECs. Clustered cotyledon embryos (0.1–0.5 cm), yellow callus. |
| Am2 | Yellow callus, medium particles, more white NECs, no proembryo differentiation. Many single cells or small cell masses, round cells, and abundant plastids. NEC cells were lightly stained and cleaved into flakes; EC cells and proembryonic cells began to lyse. Dicotyledon embryos (0.2 cm) and transparent embryos (0.2 cm). |
| Treatments | Somatic Embryo Morphology | Regenerated Plant Morphology |
|---|---|---|
| CK | Some opalescent somatic embryos. The opalescent somatic embryos varied greatly in size (0.1–1 cm); 0.5–1 cm opalescent somatic embryos were globular, while 0.2–0.4 cm opalescent somatic embryos were cotyledonous. Some calli grew and gradually browned. | Green embryos, about 2 cm stems and 7 cm roots. |
| M3Az1 | Some opalescent, globular, and clumpy embryos and dried calli. | Green and red embryos, 2 cm dark green stems and 7 cm stout taproots. |
| M3Az2 | Many transparent embryos; the original transparent embryos have been browned. | - |
| M3Az3 | Dicotyledonous embryos (0.2 cm) and transparent embryos (0.2 cm). | - |
| M3Az4 | Opalescent somatic embryos and brown transparent embryos; | - |
| Am2T3 | Some opalescent somatic embryos. The opalescent somatic embryos varied greatly in size (0.1–1 cm); 0.5–1 cm opalescent somatic embryos were globular, while 0.2–0.4 cm opalescent somatic embryos were cotyledonous. Some calli grew and gradually browned. | Red and green somatic embryos, light green 1.2 cm stems. |
| Am2Az1 | Some opalescent, globular, and clumpy embryos and dried calli. | Weak and transparent somatic embryos and 0.2 cm buds. |
| Am2Az2 | Many transparent embryos; the original transparent embryos have been browned. | - |
| Am2Az3 | Dicotyledonous embryos (0.2 cm) and transparent embryos (0.2 cm). | - |
| Am2Az4 | Opalescent somatic embryos and brown transparent embryos. | - |
| Am7T3 | Clustered cotyledonous embryos (0.1–0.5 cm), yellow calli. | Bright green somatic embryos and stems, white buds, about 0.8 cm stems, and about 4 cm roots. |
| Am7Az1 | Many 0.1 cm opalescent cotyledonous embryos, clumpy embryos, and yellow calli. | Size of somatic embryos varied greatly, with 0.6–1.5 cm stems and 4–7 cm roots. |
| Am7Az2 | Many 0.1 cm globular embryos, cotyledonous embryos, and brownish-yellow calli. | - |
| Am7Az3 | Some 0.1 cm opalescent embryos, clumpy embryos, and yellow calli. | - |
| Am7Az4 | Somatic embryo morphology. | - |
Disclaimer/Publisher’s Note: The statements, opinions and data contained in all publications are solely those of the individual author(s) and contributor(s) and not of MDPI and/or the editor(s). MDPI and/or the editor(s) disclaim responsibility for any injury to people or property resulting from any ideas, methods, instructions or products referred to in the content. |
© 2023 by the authors. Licensee MDPI, Basel, Switzerland. This article is an open access article distributed under the terms and conditions of the Creative Commons Attribution (CC BY) license (https://creativecommons.org/licenses/by/4.0/).
Share and Cite
Wang, G.; Liu, Y.; Gao, Z.; Li, H.; Wang, J. Effects of Amino Acids on Callus Proliferation and Somatic Embryogenesis in Litchi chinensis cv. ‘Feizixiao’. Horticulturae 2023, 9, 1311. https://doi.org/10.3390/horticulturae9121311
Wang G, Liu Y, Gao Z, Li H, Wang J. Effects of Amino Acids on Callus Proliferation and Somatic Embryogenesis in Litchi chinensis cv. ‘Feizixiao’. Horticulturae. 2023; 9(12):1311. https://doi.org/10.3390/horticulturae9121311
Chicago/Turabian StyleWang, Guo, Yaoting Liu, Zhaoyin Gao, Huanling Li, and Jiabao Wang. 2023. "Effects of Amino Acids on Callus Proliferation and Somatic Embryogenesis in Litchi chinensis cv. ‘Feizixiao’" Horticulturae 9, no. 12: 1311. https://doi.org/10.3390/horticulturae9121311
APA StyleWang, G., Liu, Y., Gao, Z., Li, H., & Wang, J. (2023). Effects of Amino Acids on Callus Proliferation and Somatic Embryogenesis in Litchi chinensis cv. ‘Feizixiao’. Horticulturae, 9(12), 1311. https://doi.org/10.3390/horticulturae9121311
